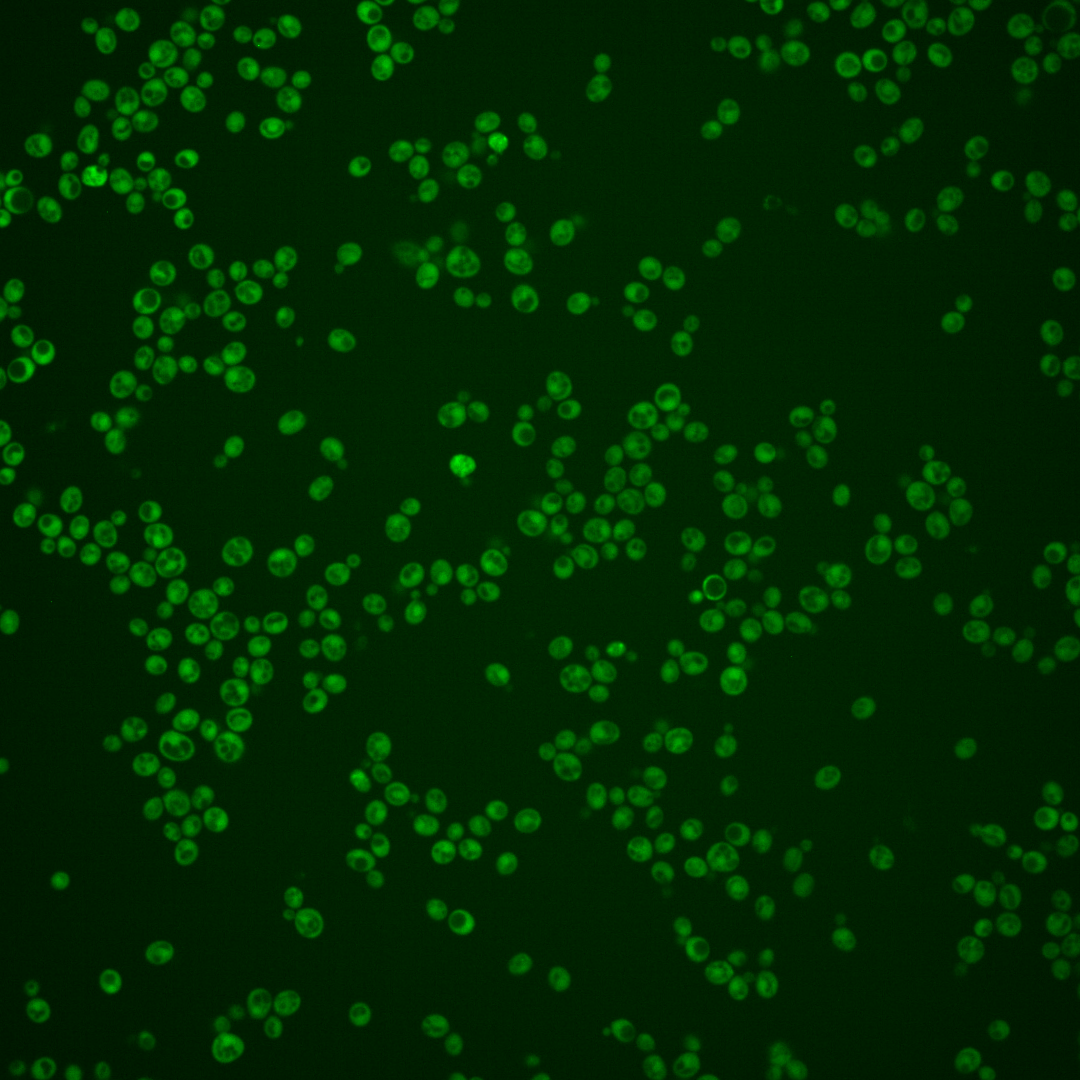
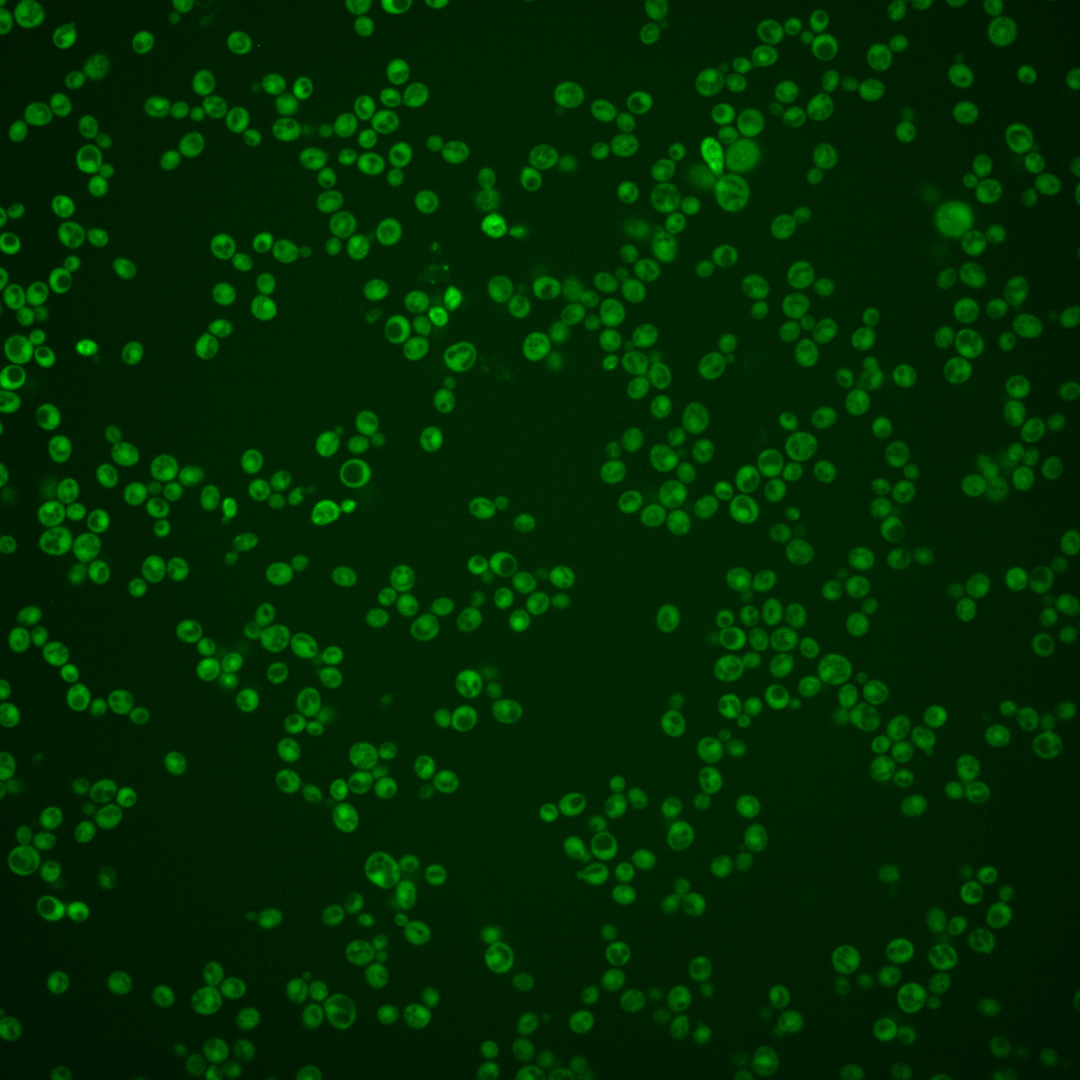
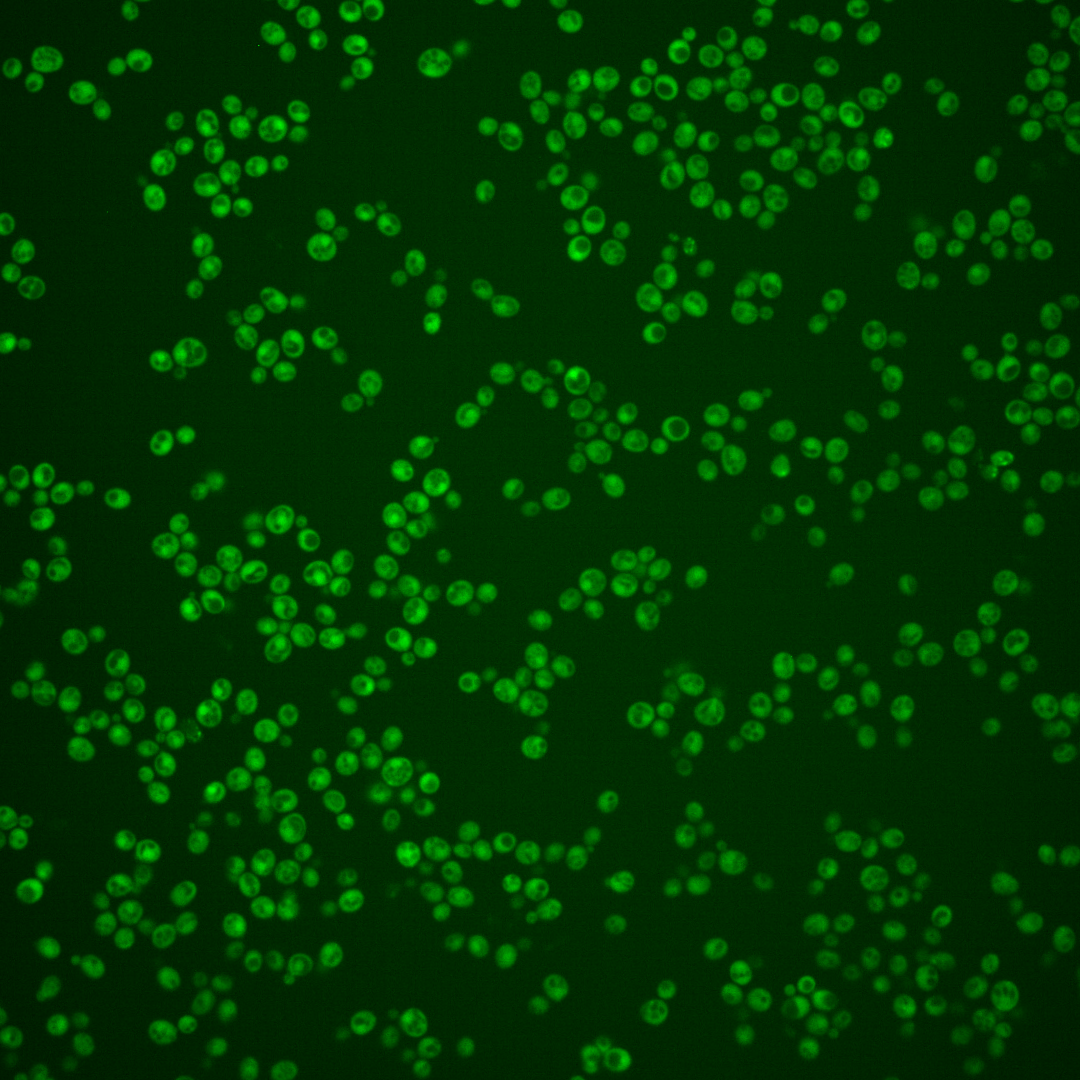

| Standard name | |
|---|---|
| Human Ortholog | |
| Description | Xylulokinase; converts D-xylulose and ATP to xylulose 5-phosphate and ADP; rate limiting step in fermentation of xylulose; required for xylose fermentation by recombinant S. cerevisiae strains |
Micrographs




















































































Sub-cellular Localization
Yeast GFP Assignment
Protein Abundance
Localization Change
External localization resources
| ensLOC | DeepLoc | |||||||||||||||||||||||
|---|---|---|---|---|---|---|---|---|---|---|---|---|---|---|---|---|---|---|---|---|---|---|---|---|
| Localization | WT1 | WT2 | WT3 | RAP60 | RAP140 | RAP220 | RAP300 | RAP380 | RAP460 | RAP540 | RAP620 | RAP700 | HU80 | HU120 | HU160 | rpd3Δ_1 | rpd3Δ_2 | rpd3Δ_3 | WT1 | WT2 | WT3 | AF100 | AF140 | AF180 |
| Cortical Patches | 0 | 0 | – | – | 0 | 0 | 0 | – | 0 | 0 | 0 | 0 | – | 0 | 0 | 0 | 0 | 0 | 1 | 0 | 0 | 0 | 0 | 0 |
| Bud | 0 | 0 | – | – | 0 | 0 | 0 | – | 0 | 1 | 2 | 1 | – | 0 | 0 | 0 | 0 | 0 | 0 | 1 | 0 | 0 | 0 | 0 |
| Bud Neck | 0 | 0 | – | – | 0 | 0 | 0 | – | 0 | 0 | 0 | 0 | – | 0 | 0 | 0 | 0 | 0 | 0 | 0 | 0 | 0 | 0 | 0 |
| Bud Site | 0 | 0 | – | – | 0 | 0 | 0 | – | 0 | 0 | 0 | 0 | – | 0 | 0 | 0 | 0 | 0 | – | – | – | – | – | – |
| Cell Periphery | 1 | 4 | – | – | 1 | 0 | 2 | – | 0 | 4 | 1 | 0 | – | 0 | 0 | 9 | 13 | 6 | 0 | 0 | 0 | 0 | 0 | 0 |
| Cytoplasm | 219 | 204 | – | – | 56 | 119 | 150 | – | 42 | 104 | 80 | 57 | – | 16 | 26 | 263 | 284 | 225 | 218 | 202 | 46 | 17 | 33 | 48 |
| Endoplasmic Reticulum | 2 | 3 | – | – | 0 | 0 | 0 | – | 1 | 1 | 0 | 0 | – | 0 | 0 | 10 | 14 | 8 | 0 | 0 | 0 | 0 | 0 | 0 |
| Endosome | 0 | 0 | – | – | 0 | 1 | 1 | – | 0 | 0 | 0 | 0 | – | 0 | 0 | 0 | 0 | 0 | 2 | 0 | 0 | 0 | 0 | 0 |
| Golgi | 0 | 1 | – | – | 0 | 0 | 0 | – | 0 | 0 | 0 | 0 | – | 0 | 0 | 2 | 1 | 0 | 0 | 2 | 0 | 0 | 0 | 0 |
| Mitochondria | 4 | 0 | – | – | 0 | 3 | 5 | – | 13 | 25 | 49 | 36 | – | 1 | 2 | 4 | 0 | 0 | 2 | 0 | 0 | 0 | 0 | 0 |
| Nucleus | 2 | 1 | – | – | 0 | 1 | 5 | – | 4 | 4 | 1 | 5 | – | 0 | 6 | 10 | 8 | 5 | 0 | 2 | 0 | 0 | 0 | 0 |
| Nuclear Periphery | 2 | 0 | – | – | 0 | 0 | 0 | – | 0 | 0 | 0 | 0 | – | 0 | 3 | 0 | 0 | 0 | 1 | 0 | 0 | 0 | 0 | 1 |
| Nucleolus | 0 | 0 | – | – | 0 | 0 | 0 | – | 0 | 0 | 0 | 1 | – | 0 | 1 | 0 | 0 | 1 | 0 | 0 | 0 | 0 | 0 | 0 |
| Peroxisomes | 0 | 0 | – | – | 0 | 0 | 0 | – | 0 | 0 | 0 | 0 | – | 0 | 0 | 0 | 0 | 0 | 0 | 0 | 0 | 0 | 0 | 0 |
| SpindlePole | 0 | 0 | – | – | 0 | 0 | 0 | – | 0 | 0 | 0 | 0 | – | 0 | 0 | 0 | 0 | 0 | 1 | 0 | 0 | 0 | 0 | 0 |
| Vac/Vac Membrane | 0 | 0 | – | – | 0 | 1 | 3 | – | 1 | 16 | 5 | 6 | – | 0 | 1 | 15 | 7 | 20 | 1 | 0 | 0 | 0 | 0 | 1 |
| Unique Cell Count | 226 | 207 | 56 | 123 | 159 | 55 | 139 | 111 | 93 | 16 | 39 | 279 | 294 | 240 | 232 | 211 | 48 | 21 | 38 | 57 | ||||
| Labelled Cell Count | 230 | 213 | 57 | 125 | 166 | 61 | 155 | 138 | 106 | 17 | 39 | 313 | 327 | 265 | 232 | 211 | 48 | 21 | 38 | 57 | ||||
Yeast GFP Assignment
Protein Abundance
| Screen | WT1 | WT2 | WT3 | RAP60 | RAP140 | RAP220 | RAP300 | RAP380 | RAP460 | RAP540 | RAP620 | RAP700 | HU80 | HU120 | HU160 | rpd3Δ_1 | rpd3Δ_2 | rpd3Δ_3 | AF100 | AF140 | AF180 |
|---|---|---|---|---|---|---|---|---|---|---|---|---|---|---|---|---|---|---|---|---|---|
| Mean Cell GFP Intensity (1e-4) | 5.2 | 6.5 | – | – | 7.7 | 7.0 | 7.3 | – | 5.7 | 6.3 | 6.0 | 5.6 | – | 6.8 | 6.0 | 14.2 | 14.7 | 13.9 | – | – | 5.9 |
| Std Deviation (1e-4) | 0.8 | 1.1 | – | – | 1.5 | 1.6 | 1.8 | – | 1.0 | 1.2 | 1.5 | 1.2 | – | 1.2 | 1.3 | 3.0 | 2.7 | 2.5 | – | – | 1.1 |
| Intensity Change (Log2) | – | – | – | – | – | – | – | – | – | – | – | – | – | – | – | – | – | – | – | – | – |
Localization Change
| Localization | RAP60 | RAP140 | RAP220 | RAP300 | RAP380 | RAP460 | RAP540 | RAP620 | RAP700 | HU80 | HU120 | HU160 | rpd3Δ_1 | rpd3Δ_2 | rpd3Δ_3 |
|---|---|---|---|---|---|---|---|---|---|---|---|---|---|---|---|
| Actin | – | – | – | – | – | – | – | – | – | – | – | – | – | – | – |
| Bud | – | – | – | – | – | – | – | – | – | – | – | – | – | – | – |
| Bud Neck | – | – | – | – | – | – | – | – | – | – | – | – | – | – | – |
| Bud Site | – | – | – | – | – | – | – | – | – | – | – | – | – | – | – |
| Cell Periphery | – | – | – | – | – | – | – | – | – | – | – | – | – | – | – |
| Cyto | – | – | – | – | – | – | – | – | – | – | – | – | – | – | – |
| Endoplasmic Reticulum | – | – | – | – | – | – | – | – | – | – | – | – | – | – | – |
| Endosome | – | – | – | – | – | – | – | – | – | – | – | – | – | – | – |
| Golgi | – | – | – | – | – | – | – | – | – | – | – | – | – | – | – |
| Mitochondria | – | – | – | – | – | – | – | – | – | – | – | – | – | – | – |
| Nuclear Periphery | – | – | – | – | – | – | – | – | – | – | – | – | – | – | – |
| Nuc | – | – | – | – | – | – | – | – | – | – | – | – | – | – | – |
| Nucleolus | – | – | – | – | – | – | – | – | – | – | – | – | – | – | – |
| Peroxisomes | – | – | – | – | – | – | – | – | – | – | – | – | – | – | – |
| SpindlePole | – | – | – | – | – | – | – | – | – | – | – | – | – | – | – |
| Vac | – | – | – | – | – | – | – | – | – | – | – | – | – | – | – |
| Cortical Patches | – | – | – | – | – | – | – | – | – | – | – | – | – | – | – |
| Cytoplasm | – | – | – | – | – | – | – | – | – | – | – | – | – | – | – |
| Nucleus | – | – | – | – | – | – | – | – | – | – | – | – | – | – | – |
| Vacuole | – | – | – | – | – | – | – | – | – | – | – | – | – | – | – |
External localization resources
Images






























Protein Concentration and Protein Localization Data
| R1 | R2 | R3 | ||||||||||||||||
|---|---|---|---|---|---|---|---|---|---|---|---|---|---|---|---|---|---|---|
| G1 Pre-START | G1 Post-START | S/G2 | Metaphase | Anaphase | Telophase | G1 Pre-START | G1 Post-START | S/G2 | Metaphase | Anaphase | Telophase | G1 Pre-START | G1 Post-START | S/G2 | Metaphase | Anaphase | Telophase | |
| Concentration | 1.0998 | 1.4575 | 1.2131 | 1.371 | 1.0689 | 1.3369 | 1.0985 | 1.4139 | 1.2384 | 0.9393 | 0.9682 | 1.2657 | 1.0025 | 1.4374 | 1.116 | 1.4433 | 1.3735 | 1.1543 |
| Actin | 0.0236 | 0.0028 | 0.0038 | 0.0335 | 0.0438 | 0.0044 | 0.0382 | 0.0006 | 0.0182 | 0.0041 | 0.046 | 0.006 | 0.0291 | 0.0078 | 0.0066 | 0.0074 | 0.0004 | 0.003 |
| Bud | 0.0011 | 0.0112 | 0.0021 | 0.0098 | 0.0036 | 0.0007 | 0.0009 | 0.0014 | 0.0028 | 0.0071 | 0.0007 | 0.0002 | 0.0007 | 0.0005 | 0.0018 | 0.0006 | 0.0001 | 0.0012 |
| Bud Neck | 0.0115 | 0.0005 | 0.0005 | 0.0024 | 0.0122 | 0.0009 | 0.005 | 0.0002 | 0.0024 | 0.0008 | 0.0005 | 0.0009 | 0.0026 | 0.0002 | 0.0006 | 0.0005 | 0.0003 | 0.0018 |
| Bud Periphery | 0.002 | 0.0062 | 0.0014 | 0.0169 | 0.0058 | 0.0007 | 0.0011 | 0.0006 | 0.0033 | 0.0123 | 0.0009 | 0.0002 | 0.0008 | 0.0005 | 0.0014 | 0.0005 | 0 | 0.0012 |
| Bud Site | 0.0102 | 0.01 | 0.005 | 0.0171 | 0.0053 | 0.0008 | 0.0086 | 0.006 | 0.0295 | 0.002 | 0.0019 | 0.0003 | 0.008 | 0.0033 | 0.0062 | 0.0007 | 0.0003 | 0.0004 |
| Cell Periphery | 0.0003 | 0.0003 | 0.0001 | 0.0006 | 0.0002 | 0.0001 | 0.0005 | 0.0001 | 0.0003 | 0.0001 | 0.0001 | 0.0001 | 0.0005 | 0.0001 | 0.0007 | 0 | 0 | 0.0001 |
| Cytoplasm | 0.408 | 0.6072 | 0.4986 | 0.4934 | 0.459 | 0.6258 | 0.4087 | 0.6247 | 0.4835 | 0.5409 | 0.4302 | 0.6102 | 0.5797 | 0.8266 | 0.7251 | 0.8201 | 0.7602 | 0.8057 |
| Cytoplasmic Foci | 0.036 | 0.0119 | 0.0191 | 0.0134 | 0.0177 | 0.0228 | 0.0369 | 0.0105 | 0.0195 | 0.0133 | 0.0771 | 0.0161 | 0.0398 | 0.0066 | 0.0112 | 0.0453 | 0.0414 | 0.0143 |
| Eisosomes | 0.0003 | 0.0001 | 0.0001 | 0.0003 | 0.0003 | 0 | 0.0009 | 0.0001 | 0.0001 | 0 | 0.0002 | 0.0001 | 0.0006 | 0 | 0.0001 | 0 | 0 | 0 |
| Endoplasmic Reticulum | 0.0024 | 0.0018 | 0.0023 | 0.0056 | 0.0037 | 0.0027 | 0.008 | 0.0011 | 0.0029 | 0.0012 | 0.0033 | 0.002 | 0.0074 | 0.0012 | 0.0037 | 0.0015 | 0.0026 | 0.0023 |
| Endosome | 0.0181 | 0.0056 | 0.0121 | 0.0048 | 0.0132 | 0.0068 | 0.0259 | 0.0014 | 0.0049 | 0.0015 | 0.0573 | 0.0103 | 0.0377 | 0.0011 | 0.0136 | 0.011 | 0.0104 | 0.0157 |
| Golgi | 0.0057 | 0.0004 | 0.003 | 0.0015 | 0.0105 | 0.0011 | 0.0082 | 0.0002 | 0.0025 | 0.0015 | 0.0133 | 0.0066 | 0.0119 | 0.002 | 0.0108 | 0.008 | 0.0015 | 0.0089 |
| Lipid Particles | 0.0079 | 0.0002 | 0.004 | 0.002 | 0.0015 | 0.0034 | 0.017 | 0.0002 | 0.0037 | 0.0003 | 0.0325 | 0.0048 | 0.0112 | 0.0001 | 0.0051 | 0.0021 | 0.0034 | 0.001 |
| Mitochondria | 0.0033 | 0.0011 | 0.0048 | 0.0013 | 0.0423 | 0.0051 | 0.0035 | 0.0002 | 0.0016 | 0.0024 | 0.0084 | 0.0097 | 0.013 | 0.0014 | 0.0076 | 0.0009 | 0.0003 | 0.0022 |
| None | 0.4382 | 0.3306 | 0.4233 | 0.3762 | 0.3504 | 0.3005 | 0.3831 | 0.3449 | 0.3904 | 0.3572 | 0.2519 | 0.3198 | 0.2073 | 0.1451 | 0.1816 | 0.0731 | 0.1436 | 0.1286 |
| Nuclear Periphery | 0.0054 | 0.0009 | 0.0032 | 0.0041 | 0.0098 | 0.0015 | 0.0151 | 0.0005 | 0.0013 | 0.0004 | 0.0147 | 0.0034 | 0.0049 | 0.0003 | 0.0015 | 0.0007 | 0.0012 | 0.0016 |
| Nucleolus | 0.001 | 0.0004 | 0.0005 | 0.0003 | 0.0005 | 0.0003 | 0.0008 | 0.0002 | 0.0007 | 0.0001 | 0.0007 | 0.0002 | 0.0006 | 0 | 0.0002 | 0.0001 | 0.0004 | 0.0002 |
| Nucleus | 0.0033 | 0.004 | 0.0036 | 0.0047 | 0.007 | 0.0068 | 0.0043 | 0.0029 | 0.0025 | 0.002 | 0.0028 | 0.0023 | 0.005 | 0.0011 | 0.0019 | 0.0025 | 0.0038 | 0.0038 |
| Peroxisomes | 0.0124 | 0.0013 | 0.002 | 0.0046 | 0.0041 | 0.0085 | 0.0191 | 0.0007 | 0.0254 | 0.0519 | 0.0214 | 0.0016 | 0.0273 | 0.0014 | 0.0139 | 0.0219 | 0.0085 | 0.0034 |
| Punctate Nuclear | 0.0064 | 0.0019 | 0.0067 | 0.005 | 0.0054 | 0.0062 | 0.0103 | 0.0027 | 0.0031 | 0.0006 | 0.029 | 0.0041 | 0.0059 | 0.0002 | 0.0007 | 0.0025 | 0.0209 | 0.0036 |
| Vacuole | 0.002 | 0.0014 | 0.0021 | 0.0021 | 0.002 | 0.0008 | 0.0023 | 0.0007 | 0.0012 | 0.0004 | 0.003 | 0.0007 | 0.0047 | 0.0005 | 0.0052 | 0.0007 | 0.0006 | 0.0008 |
| Vacuole Periphery | 0.0008 | 0.0002 | 0.0017 | 0.0005 | 0.0015 | 0.0002 | 0.0017 | 0.0001 | 0.0002 | 0.0001 | 0.0038 | 0.0005 | 0.0013 | 0 | 0.001 | 0.0002 | 0.0001 | 0.0003 |
Sequencing Data
| R1 | R2 | |||||||||
|---|---|---|---|---|---|---|---|---|---|---|
| G1 Post-START | S/G2 | Metaphase | Anaphase | Telophase | G1 Post-START | S/G2 | Metaphase | Anaphase | Telophase | |
| Gene Expression | 4.8959 | 4.3766 | 2.4357 | 7.7798 | 9.5215 | 4.2815 | 10.3715 | 11.9468 | 13.1543 | 9.7608 |
| Translational Efficiency | 0.8671 | 0.9547 | 1.589 | 0.9212 | 0.5912 | 1.4125 | 0.8336 | 0.8722 | 0.9578 | 0.8576 |
Hit Data
| Dataset | Hit |
|---|---|
| Protein Concentration | ✔ |
| Protein Localization | ✘ |
| Gene Expression | ✘ |
| Translational Efficiency | ✘ |
Endocytosis
| Temp | Actin Patch (Sac6-tdTomato) | Cortical Patch (Sla1-GFP) | Late Endosome (Snf7-GFP) | Vacuole (Vph1-GFP) |
|---|---|---|---|---|
| 37℃ | ||||
| RT |
Cell Cycle Omics
CYCLoPs (Xks1-GFP)
| Gene / Allele | Actin Patch (Sac6-tdTomato) | Cortical Patch (Sla1-GFP) | Late Endosome (Snf7-GFP) | Vacuole (Sac6-tdTomato) |
|---|
| Gene | Images |
|---|
| Gene | Images |
|---|
Images are not yet available
Images are not yet available